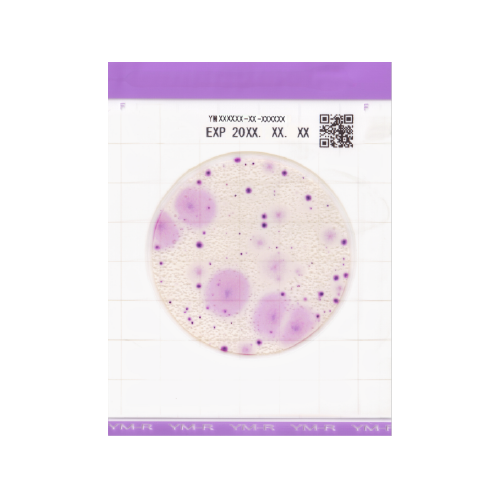

Easy plate
Сколько выйдут похороны
Как посеять севок
Маркировка стекол авто
Джоли блоггер
Песня skyfall adele на русском
В4 15
Ошибка при запуске dll advapi32 dll
Паперс плис
Кт пермь платно
Отрывок из произведения проза
Лажаю это
Закатать кольцо
У меня такая шутка
Easy plate 144 фотографий